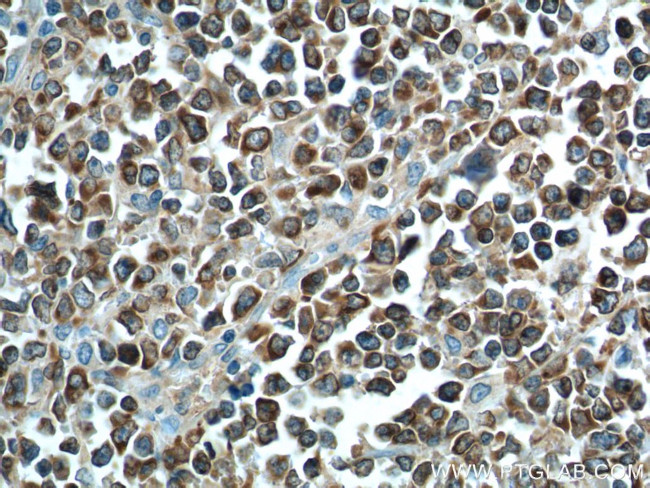
BCL2 Antibody in Immunohistochemistry (Paraffin) (IHC (P))

Search
Proteintech
BCL2 Polyclonal Antibody
{{$productOrderCtrl.translations['antibody.pdp.commerceCard.promotion.promotions']}}
{{$productOrderCtrl.translations['antibody.pdp.commerceCard.promotion.viewpromo']}}
{{$productOrderCtrl.translations['antibody.pdp.commerceCard.promotion.promocode']}}: {{promo.promoCode}} {{promo.promoTitle}} {{promo.promoDescription}}. {{$productOrderCtrl.translations['antibody.pdp.commerceCard.promotion.learnmore']}}





















Please note: We are reviewing Western blot images included in the antibody testing data in our catalog, including those provided by third parties. Unless expressly labeled or annotated as “raw-unedited”, Western blot images included in the antibody testing data in our catalog may have been edited, optimized or otherwise adjusted for presentation.
产品信息
12789-1-AP
种属反应
已发表种属
宿主/亚型
分类
类型
抗原
偶联物
形式
浓度
规格
纯化类型
保存液
内含物
保存条件
运输条件
产品详细信息
This antibody is not suitable for rat and mouse species.
Immunogen sequence: MAHAGRTGY DNREIVMKYI HYKLSQRGYE WDAGDVGAAP PGAAPAPGIF SSQPGHTPHP AASRDPVART SPLQTPAAPG AAAGPALSPV PPVVHLTLRQ AGDDFSRRYR RDFAEMSSQL HLTPFTARGR FATVVEELFR DGVNWGRIVA FFEFGGVMCV ESVNREMSPL VDNIALWMTE YLNRHLHTWI QDNGGWDAFV ELYGPSMRPL FDFSWLSLKT LLSLALVGAC ITLGAYLGHK (1-239 aa encoded by BC027258)
靶标信息
BCL-2 is a key regulator of apoptosis that functions to either inhibit or promote cell death. The BCL-2 family members are also characterized by dimerizing to further modulate apoptosis. Bag1, for example, has been found to form a heterodimer with BCL-2 resulting in the enhancement of the anti-apoptotic effect of BCL-2. Bax and Bak have been shown to play a critical role in cytochrome c release from mitochondria and thus initiate apoptosis. Bax exerts a pro-apoptotic rather than an anti-apoptotic effect on cells. Constitutive expression of BCL2, such as in the case of translocation of BCL2 to Ig heavy chain locus, is thought to be the cause of follicular lymphoma. In most follicular lymphomas, neoplastic germinal centers express high levels of BCL-2 alpha protein, whereas the normal or hyperplastic germinal centers are negative. Two transcript variants of BCL-2, produced by alternate splicing, differ in their C-terminal ends. The overexpression of BCL-2 has been linked to human cancers such as B-cell lymphoma and prostate cancer.
仅用于科研。不用于诊断过程。未经明确授权不得转售。
生物信息学
蛋白别名: Apoptosis regulator Bcl-2; B-cell CLL/lymphoma 2; Bcl 2; bcl-2 protein; bcl2-alpha protein; bcl2-beta protein; bcl2-Ig fusion gene; OTTHUMP00000163680; protein phosphatase 1, regulatory subunit 50
基因别名: Bcl-2; BCL2; PPP1R50
Entrez Gene ID: (Human) 596